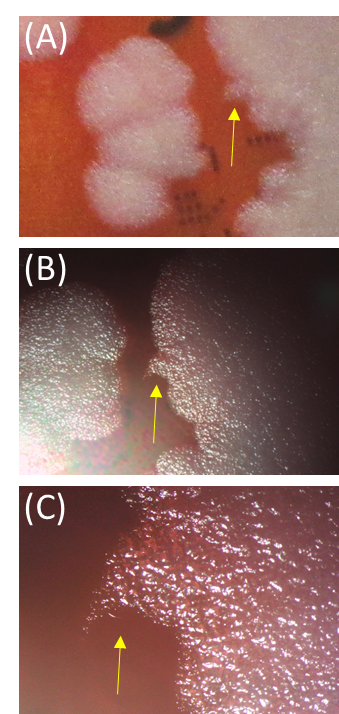
anthrax 180425 f1

炭疽(詳細版)
更新作業中のため、ページの一部に古い情報が含まれる場合があります。
(2018年04月25日改訂)
(2024年1月26日一部修正)
炭疽(anthrax)は炭疽菌(Bacillus anthracis)を起因菌とする急性敗血症性の動物由来感染症であり、感染症法で4類感染症に指定されている。炭疽菌は二種病原体等に指定され、バイオセーフティレベル3施設での取扱いを要する。炭疽はウシやウマなどの草食獣で感受性が高い。ヒトは感染動物や炭疽菌芽胞に汚染した動物製品などから感染する(参考文献1、2)。
疫学
炭疽は世界の多くの地域で発生している。炭疽菌は酸素と接触することによって芽胞を形成して、熱、乾燥、消毒薬などに対する強い抵抗性を獲得し、土壌中などで長期間生存し、動物に感染を繰り返す。芽胞が生体内に侵入すると発芽し、栄養型として体内で急速に増殖して炭疽を発症する。感染動物の血液、体液、死体などで汚染された土壌中の芽胞は再び感染源となる。炭疽菌はこのような感染サイクルを繰り返して、炭疽汚染地帯を作る。世界的にはスペイン中部からギリシャ、トルコを経てイラン、パキスタンに及ぶ汚染地域があり炭疽ベルトとも呼ばれる。また、南アメリカ、中央アジア、中央アフリカなどでも発生がみられる。ヒトおよび動物の炭疽の発生は途上国や家畜衛生が立ち後れている国に多い。先進国での炭疽は、動物組織の処理過程での孤発的発生が多い。ヒトおよび動物の炭疽菌の自然感染は偶発的に摂取あるいは接触した芽胞が原因であり、炭疽菌が個体から個体へ直接伝播されることはほとんどない。
日本における炭疽の発生例は、ヒトでは1994年の皮膚炭疽の報告、動物では2000年の牛の炭疽の報告を最後に発生していない。しかし第二次大戦以前には牛で年間100頭以上、馬で年間数十頭の炭疽が国内で報告されていた。炭疽菌の芽胞は土壌中で長期間安定であることから発生リスクが無いとはいえない。また欧米ではアフリカ由来の皮革から作られたドラムに付着していた炭疽菌の芽胞による炭疽が報告されており、芽胞に汚染された動物由来製品の輸入を介した炭疽のリスクも低いながらある。一方、2001年の米国での炭疽菌の芽胞による生物テロ事件により、自然発生例よりも炭疽菌の芽胞を利用した生物テロの可能性が公衆衛生上の問題となっている。
病原体
写真1:炭疽菌のヒツジ血液寒天培地コロニー周縁部の縮毛状(medusa head)部分(A)および実体顕微鏡像(B,C)(黄色矢印)
炭疽菌は通性嫌気性グラム陽性有芽胞大型桿菌であり、栄養型は長さ3~5μm、幅1~1.2μmで芽胞は長さ約2μm、幅0.5μmである。血液中では菌体の最外層に莢膜を発現する。鞭毛を欠き運動性がない。ヒツジ血液寒天培地上に非溶血性、灰色で周縁不整、縮毛状の大型集落を形成する。実体顕微鏡下では、コロニー周辺部が縮毛状(medusa head)であることが観察される(写真1)。炭疽菌は感染動物の体内では菌体表層に莢膜を形成した単在か短連鎖であるが、人工培地で培養すると並列または絡み合った状態の断節的な竹節状の長連鎖を呈する(写真2)。
炭疽菌の病原因子は浮腫毒、致死毒、防御抗原である。浮腫毒と致死毒は防御抗原によって感染宿主の細胞膜上の受容体タンパク質に結合し細胞内に輸送される。最終的に浮腫毒と致死毒は細胞質内に放出される。炭疽により動物が死亡するのは、致死毒による毒血症によると考えられている。浮腫毒と致死毒および防御抗原は毒素プラスミドpXO1に、莢膜は莢膜プラスミドpXO2にコードされている。野外から分離される強毒株は、通常この2種類のプラスミドを保有する。莢膜はD体アミノ酸であるグルタミン酸から成るポリグルタミン酸で構成されており、生体の免疫細胞による食作用を受けにくい。また、アフリカではpXO1、pXO2様プラスミドを有するセレウス菌による炭疽様感染症の発生が報告されている(参考文献3、4)。また、炭疽菌は他のバチルス属の細菌と同じように染色体上に2種類のβ-ラクタマーゼ(ペニシリナーゼとメタロ-β-ラクタマーゼ)の遺伝子を保有していることが多く、それらが発現した株では、ペニシリン系やセファロスポリン系に耐性を示すことがある。
写真2:並列または絡み合った状態の断節的な竹節状の炭疽菌の長連鎖像(×400倍)

臨床症状
ヒトの病型は伝播様式によって皮膚炭疽(経皮感染)、腸炭疽(経口感染)、および肺炭疽(吸入感染)の3種に分けられる。各病態における病変の写真等は、バイオテロ対応ホームページ(http://h-crisis.niph.go.jp/bt/disease/1summary/1images/(外部サイトにリンクします))を参照されたい。
- 皮膚炭疽
自然感染の95%以上は皮膚炭疽である。創傷部から芽胞が体内に取り込まれ、1~10日後に小さな掻痒性、無痛の丘疹が出現する。周囲には発疹と浮腫が出現する。局所リンパ節の腫脹が著しい。未治療の場合の致命率は10~20%とされる。 - 腸炭疽
炭疽菌芽胞に汚染した食肉や食品を摂食することで発症する。悪心、嘔吐、食欲低下、発熱で始まる。2~3日後、激しい腹痛と血液を含む下痢を呈する。これらの激しい症状の後、毒血症、ショック、死亡に至ることがある。病変は盲腸に認められ、ときに他の大腸部や十二指腸にも認められる。未治療の場合の致命率は25~50%とされる。 - 肺炭疽
芽胞の吸入により感染する。自然感染による発生は極めて稀である。感染初期はインフルエンザ様症状(軽度の発熱、倦怠感、筋肉痛など)、または気管支肺炎様症状を示し、発熱、呼吸困難、咳、頭痛、嘔吐、悪寒、脱力、腹部と胸部の疼痛が見られる。胸水を伴った肺縦隔の拡張がある。未治療の場合、致命率は90%以上に達する。
動物における炭疽は、草食獣、特にウシやウマなどに多い。甚急性感染、急性感染、および亜急性/慢性感染の病型が知られている。症状は眼結膜の充血、可視粘膜の浮腫、呼吸困難などで、感受性の強い動物は、急性敗血症や尿毒症による腎障害を呈して死亡する。家畜伝染病予防法では牛、馬、めん羊、山羊、豚の炭疽が家畜伝染病に指定されている。
病原診断
炭疽の確定診断は炭疽菌の分離同定によって行う。検体の直接染色によりグラム陽性芽胞形成性の桿菌、寒天培地上で特徴的な集落の形成などがみられ、血液寒天培地で非溶血性・運動性がない場合には、炭疽菌を疑う。さらに、ガンマファージテスト、パールテスト等を行って陽性であれば、炭疽菌と確定できる。アスコリーテストは菌量が少なかったり、古い材料では陰性となることがあるので注意を要する。
他の診断方法として、莢膜染色(レビーゲル染色)、抗原検出法、PCR法などがある。PCR法では、炭疽菌の防御抗原や莢膜抗原などの遺伝子を標的として検出する。PCR法の利点は他の菌が混入していても検出できる点と、試料の新鮮さを問わない点であり、病原診断にきわめて有用である。
治療・予防
炭疽は、皮膚炭疽、肺炭疽、腸炭疽に大別され、髄膜炎の合併の有無により治療で用いる抗菌薬が異なる。このため、全身症状を伴う場合、禁忌がない限り腰椎穿刺により髄膜炎合併の有無を評価すべきである。治療は抗菌薬以外に、外科的治療、抗毒素(免疫グロブリン製剤、ヒトモノクローナル抗体)に加え全身管理(補液、酸素投与、気道確保、昇圧剤投与等)を含めた治療も重要である。
抗菌薬について
ペニシリナーゼを産生しない炭疽菌は,ペニシリン系薬剤,クロラムフェニコール,テトラサイクリン,エリスロマイシン,ストレプトマイシン,フルオロキノロン系薬剤等の多くの抗菌薬に感受性がある。一方で,セフェム系薬剤,ST合剤には自然耐性である。なおペニシリナーゼ産生株の報告があるため,感受性が判明するまではペニシリン系薬剤単剤での治療は行わない。成人への処方例を表に示した(参考文献5、6)。妊婦・小児への処方例は参考文献6-8を参照されたい。
汚染の除去、消毒および滅菌
汚染された可能性のある衣服(靴、ソックス、ストッキング、および袖や襟が汚
染された場合には上着)はできるだけ早く脱衣して、缶かバッグに入れ、消毒やオートクレーブ処理を行う。最終消毒の終了後、室内あるいは動物舎のような閉鎖空間は十分に換気を行い、消毒剤が人体に悪影響を及ぼさないように注意してから再使用する。
なお、芽胞を効果的に消毒するのはきわめて困難であり、状況によってはこれを完全に実施するのは不可能な場合がある。また、消毒作業の効果を推定することはできないので、確認する場合は、スワブを採取して培養によって確かめる。
- 10%ホルムアルデヒド(30%ホルマリン)…1~1.5L/m2、2時間、10℃以上
- 4%グルタルアルデヒド(pH8.0~8.5)…1~1.5L/m2、2時間、10℃以上
- 3%過酸化水素水…0.5L/m2、2時間
- 1%過酢酸…0.5L/m2、2時間
- 焼却
- オートクレーブ処理…121℃20~30分
消毒方法の基準については、と畜検査実施要領(昭和47年5月27日環乳第48号)の別表「消毒方法の基準」を参照されたい。https://www.mhlw.go.jp/web/t_doc?dataId=00tb5872&dataType=1&pageNo=1(外部サイトにリンクします)
表

別表

感染症法における取り扱い(2018年4月時点)
全数報告対象(4類感染症)であり、診断した医師は直ちに最寄りの保健所に届け出なければならない。
届出基準はこちら(外部サイトにリンクします)
参考文献
- Guidelines for the Surveillance and Control of Anthrax in Humans and Animals. WHO/EMC/ZDI/98/6.
https://iris.who.int/handle/10665/59516(外部サイトにリンクします) - Anthrax in humans and animals. 4th edition. OIE/WHO/FAO.2008.
https://iris.who.int/handle/10665/97503(外部サイトにリンクします) - Characterization of Bacillus anthracis-like bacteria isolated from wild great apes from Cote d'Ivoire and Cameroon. J Bacteriol. 2006 Aug;188(15):5333-44.
- Bacillus cereus Biovar Anthracis Causing Anthrax in Sub-Saharan Africa-Chromosomal Monophyly and Broad Geographic Distribution. PLoS Negl Trop Dis. 2016 Sep 8;10(9):e0004923. doi: 10.1371/journal.pntd.0004923.
- Clinical Framework and Medical Countermeasure Use During an Anthrax Mass-Casualty Incident. CDC Recommendations. MMWR 64(4), 2015
https://www.cdc.gov/mmwr/pdf/rr/rr6404.pdf(外部サイトにリンクします) - 炭疽菌による生物テロへの公衆衛生対応2016.保健医療科学65号6巻p548-560.
https://www.niph.go.jp/journal/data/65-6/201665060004.pdf(外部サイトにリンクします) - Pediatric anthrax clinical management. Pediatirics. 2014;133:e1411-1436.
- Special considerations for prophylaxis for and treatment of anthrax in pregnant and postpartum women. Emerg Infect Dis. 2014;20(2).
(国立感染症研究所 獣医科学部 奥谷晶子)
